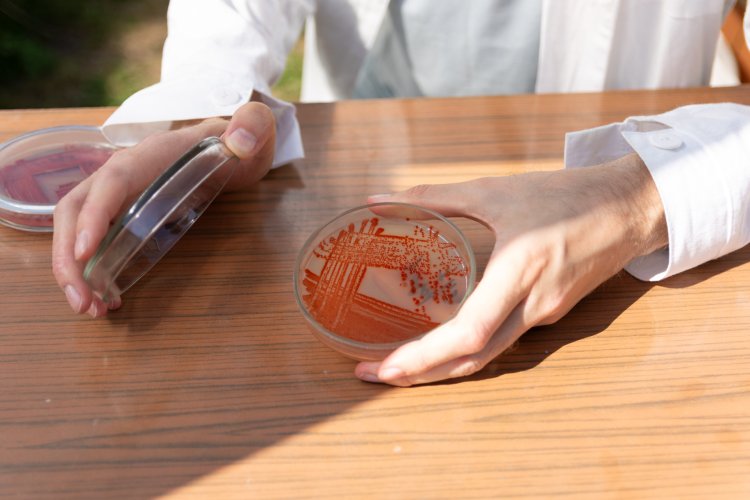

Результаты исследования, выполненного при поддержке Российского научного фонда (РНФ), опубликованы в журнале Applied Microbiology (ред. - Пресс-служба РНФ).
«По данным ФАО ООН, еще в 2017 году 21% сельскохозяйственных земель РФ были засоленными территориями. И пока ситуация не улучшается. Засоление почв — это серьезная для аграриев России и других стран проблема. Засоленность серьезно ограничивает урожайность сельскохозяйственных культур, поскольку избыток солей вызывает осмотическую и ионно-специфическую токсичность у растений, они медленно растут и не плодоносят. Одним из вариантов решения этой проблемы является повышение солеустойчивости растений за счет использования биоудобрений. В основе таких удобрений ризобактерии, которые “адаптируют” растения к сложным условиям и стимулируют их рост», — поясняет доцент кафедры экспериментальной биологии и биотехнологий УрФУ Анастасия Тугбаева.
Целью работы биологов УрФУ было найти штаммы бактерий, которые помогут выживать пшенице — стратегически важной сельскохозяйственной культуре для России, на которую в 2025 году в нашей стране приходилось 62% посевных площадей зерновых.
«Почвенные бактерии, входящие в состав ризобиома — сообщества микроорганизмов, обитающих в зоне корней растений, — в большинстве случаев безопасны для растений, почвы и человека. Некоторые из них способны вступать в симбиоз с растениями. Например, у бобовых культур специальные бактерии — ризобии — образуют на корнях клубеньки, где фиксируют атмосферный азот, превращая его в доступные для растения соединения, и получают от растения углеводы, — добавляет Анастасия Тугбаева. — Биоудобрения на основе таких бактерий отличаются от минеральных удобрений, таких как синтетический аммиак или нитраты. Они содержат живые микроорганизмы, которые помогают растениям усваивать питательные вещества из почвы. При этом биоудобрения обладают пролонгированным действием: бактерии продолжают работать в течение вегетации, синтезируя фитогормоны и увеличивая доступность питательных веществ, что стимулирует рост и устойчивость растений».
Для поиска таких бактерий биологи собрали образцы Лебеды простертой и почв на засоленных озерах Челябинской и Курганской областей (Курги и Атавлы соответственно). Выделили 12 штаммов бактерий, два из которых — AP9 (с озера Атавлы) и AP12 (с озера Курги) — показали хорошие результаты в засоленных и сильно засоленных условиях.
.jpg)
Источник: Пресс-служба УрФУ
Семена пшеницы мягкой, или обыкновенной (самый распространенный в мире вид пшеницы, составляет около 90–95% мировых посевов этой зерновой культуры), перед посевом обработали биопрепаратом с отобранными штаммами бактерий. В результате устойчивость сеянцев к солевому стрессу повысилась, улучшились их морфофизиологические характеристики, поясняют ученые.
«Обработка семян пшеницы двумя штаммами показала хорошие результаты. В частности, у пшеницы повысилась солеустойчивость, снизился окислительный стресс, поддерживался рост растений, увеличилось количество первичных корней, за счет чего увеличилась площадь впитывающей поверхности и эффективность поглощения воды и минералов, — поясняет старший преподаватель кафедры экспериментальной биологии и биотехнологий УрФУ Ольга Воропаева. — Обработка семян штаммом AP12 показала наиболее выраженный положительный эффект на рост корней и побегов пшеницы в условиях крайне высокой засоленности — 225 мМ. Для понимания — это критические значения, при которых почва считается солончаковатой и непригодной для большинства растений».
Биоудобрениями с такими бактериями можно обрабатывать семена до посева, добавлять в почву (поливать раствором или вносить в сухом виде) либо обрабатывать растения по листу. Наиболее продуктивный способ еще предстоит определить, добавляют исследователи. На сегодня ученые подобрали оптимальную концентрацию бактерий для препаратов, при которой нет дефицита и перегрузки растений бактериями. С учетом этой концентрации и можно будет создавать биоудобрения, поясняют биологи. При этом в теории бактерии могут помогать и другим культурам (не только пшенице), но это предстоит проверить отдельными экспериментами.
«Мы работаем над созданием биоудобрений для злаков. Однако принцип действия бактерий универсален — они стимулируют рост растений через синтез фитогормонов и улучшение усвоения питательных веществ, поэтому теоретически они могут быть применимы к другим растениям, но расширение применения на другие культуры потребует дополнительной проверки», — поясняет Ольга Воропаева.
Для производства новых биоудобрений необходима инфраструктура для выращивания микроорганизмов в контролируемых условиях, включая биореактор или культиватор, помещение для работы с культурами и оборудование для концентрации бактерий (например, центрифуга). Однако с точки зрения биоэкономики, новые биоудобрения окупаемы, полагают ученые. Биоудобрения — это устойчивый и экологически безопасный продукт, который при масштабировании становится экономически выгодным: одноразовая обработка семян или внесение в почву заменяет часть традиционных химических удобрений, снижает потери питательных веществ и уменьшает воздействие на окружающую среду. Таким образом, инвестиции в начальную инфраструктуру окупаются за счет долгосрочной экономии и экологической эффективности, заключают ученые.

